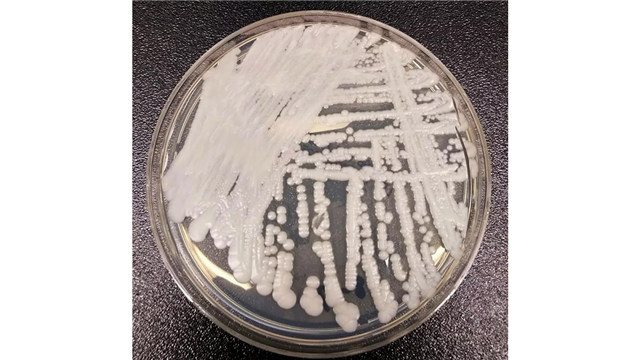
培养皿中的耳念珠菌菌株
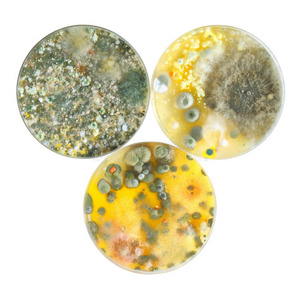
室技术员在微生物学实验室培养皿苔藓和真菌显微镜下医生检查下放大镜
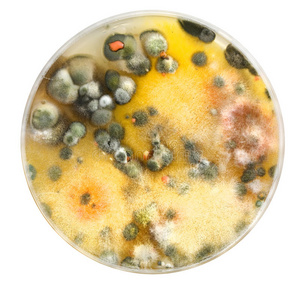
真菌培养图片

真菌培养皿

真菌,皮氏培养皿,白色背景,在上面,盘子
图片尺寸1200x795
在黑色背景下分离的皮氏培养皿上的真菌宏
图片尺寸1200x817
培养皿中的绿僵菌
图片尺寸2296x2304
真菌,皮氏培养皿,大群动物,细菌,有营养的
图片尺寸1200x795
真菌,皮氏培养皿,选择对焦,水平画幅,孢子
图片尺寸1200x800
培养皿中的耳念珠菌菌株
图片尺寸640x360
实验室,真菌,细菌,皮氏培养皿,生物科技
图片尺寸1200x800
请帮忙看一下这个霉菌培养的培养皿上生长的是类似哪种菌?
图片尺寸4160x3120
资料图:培养皿中的"超级真菌".图/ic photo
图片尺寸1080x721
室技术员在微生物学实验室培养皿苔藓和真菌显微镜下医生检查下放大镜
图片尺寸300x300
培养皿培养的真菌
图片尺寸2000x4235
真菌培养图片
图片尺寸300x300
造成脚气的真菌,如果放在培养皿上培养,会变成蘑菇或肉眼可见的东西吗
图片尺寸3264x2448
培养皿上的真菌宏
图片尺寸1200x801
培养皿与黑色和黄色真菌在科学微生物学实验室中种植样本后.
图片尺寸700x573
培养皿上的真菌宏
图片尺寸1200x796
造成脚气的真菌,如果放在培养皿上培养,会变成蘑菇或肉眼可见的东西吗
图片尺寸720x898
在培养皿中检测面包中的真菌,在实验室中检测教育药品.图片下载
图片尺寸800x533
你家娃的手有多脏科学家母亲告诉你
图片尺寸600x544
培养皿中的耳念珠菌菌株.图源:美国cdc官网
图片尺寸1024x1099